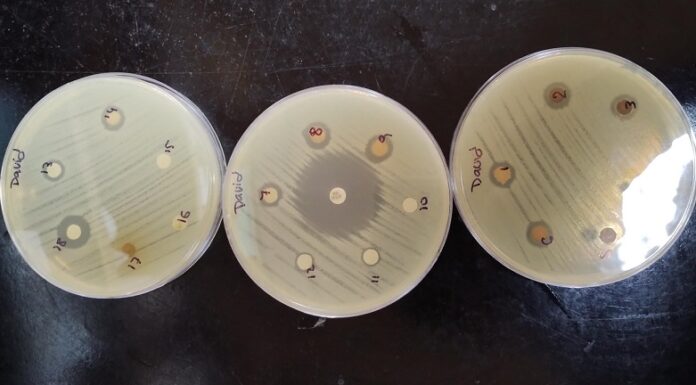
NUEVOS CONOCIMIENTOS Nanopartículas de plata: una solución innovadora contra las infecciones

La estudiante de la Licenciatura en Educación Inicial de la UNNE Martina Vazquez, relevó documentos que tuvieron como foco al Trabajo Infantil en debates...
El doctor Gustavo Adolfo Aucar, docente e investigador de la Universidad Nacional del Nordeste (UNNE) y del CONICET, ha sido invitado a participar como...
Con dos jornadas de trabajo encabezada por el Dr. Juan Manuel Pérez Saez, investigador del reconocido Laboratorio de Glicomedicina (IBYME-CONICET), se concretó un nuevo...
Un estudiante de la FaCENA de la UNNE está desarrollando nanopartículas de plata con propiedades antimicrobianas utilizando un método "verde" a partir de plantas...
Nazarena Leiva Sanz, accedió a una Beca de Estímulo a las Vocaciones Científicas (EVC-CIN) para investigar la posibilidad de diagnosticar el derrame pleural tuberculoso,...
Una investigación del Centro de Ecología Aplicada del Litoral (“CECOAL”, CONICET-UNNE) analizó los incendios ocurridos en el año 2022 en la reserva Iberá, aplicando...
En el marco de estudios sobre las interacciones de pájaros carpinteros con el Bosque Atlántico en la provincia de Misiones, investigadores del Centro de...
Por medio de ensayos en modelos murinos, una investigación del Laboratorio de Investigaciones Bioquímicas (LIBIM, UNNE-CONICET) identificó propiedades antiinflamatorias y antioxidantes en harinas integrales...
El Laboratorio de Química Analítica Instrumental de la Facultad de Ciencias Exactas de la Universidad Nacional del Nordeste es una referencia en el análisis...
La Universidad Nacional del Nordeste apoya la 1º Jornada de Innovación Abierta del NEA, que se realizará el próximo 24 de abril en Resistencia....